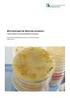
Mikrobiologische Befunde verstehen

Grundfutteranalysen verstehen
|
|
|
- Caroline Wetzel
- vor 8 Jahren
- Abrufe
Transkript
1 Grundfutteranalysen verstehen Grassilage, Maissilage, Heu Beratungsstelle Rinderproduktion Stand:
2 Inhaltsverzeichnis Futtermittel untersuchen lassen... 3 Grassilage und Kleegrassilage... 4 Maissilage... 5 Belüftungsheu und Bodenheu... 6 Zusammengestellt von: DI Franz Tiefenthaller / Referat Fütterung Grundfutteranalysen verstehen 2/8
3 Futtermittel untersuchen lassen Futtermittel sollten immer wieder untersucht werden. Speziell Grundfuttermittel variieren in ihrer Qualität sehr stark. Einflüsse sind unter anderem Witterung, Standort, Düngung und Erntezeitpunkt. Voraussetzung für eine sinnvolle Untersuchung ist eine möglichst repräsentative Probenziehung. Bei Silagen sind mehrere Einstiche durch alle Futterhorizonte in Fahrsilos bzw. bei Rundballen Proben aus mehreren Ballen notwendig. Auch Heuproben sollten, nach Schnitten getrennt, immer den gesamten Futterstock umfassen. Die Qualität von Futtermitteln wird auf mehrere Arten ermittelt: Sinnenbewertung, sensorische Beurteilung Chemische Analyse, Laboruntersuchung Die sensorische Beurteilung erfolgt durch die Sinne und umfasst im wesentlichen Farbe, Geruch und Gefüge. Mit dieser einfachen Beurteilung lassen sich bereits gute Rückschlüsse auf die Akzeptanz und die generelle Eignung eines Futtermittel zur Fütterung an die jeweilige Tierart ziehen. Sie kann bei Grund- und Kraftfuttermitteln angewendet werden. Sie ersetzt nicht die Laboranalyse sondern ist eine sinnvolle Ergänzung dazu. Denn Farbe oder Geruch können durch die chemische Untersuchung nicht erfasst werden. Die chemische Laboranalyse der Futtermittel - im speziellen der Grundfutter - ermöglicht eine objektive Einschätzung der Futterinhaltsstoffe. Erst durch die Bestimmung aller fütterungsrelevanten Inhaltsstoffe ist eine gezielte Beratung und Rationsoptimierung möglich. Im Futtermittellabor Rosenau der Landwirtschaftskammer NÖ werden alle relevanten Inhaltsstoffe analysiert und rasch an den Einsender weitergeleitet. Neben der klassischen Nasschemie werden seit 2014 bei den Rohnährstoffen auch Schnellbestimmungen mit Nahinfrarotreflexionsspektroskopie (NIRS) angeboten. Diese Methode ist schneller und günstiger als die Nasschemie, aber nicht für alle Futtermittel anwendbar. NIRS wird seit Jahren auch in Deutschland und Holland angewendet. Die Verlässlichkeit der NIRS-Analysewerte hängt von einer guten Kalibration durch Parallelbestimmungen auf nasschemischer Basis ab. Rosenau hat über 10 Jahre aufgewendet, um eine sehr genaue Kalibrierung zu erreichen, die Werte passen daher sehr gut mit den nasschemischen Analysewerten überein. Eine Untersuchung mit der NIRS-Technologie kann daher bei folgenden Futtermitteln empfohlen werden: Gras, Grassilage, Kleegras, Heu Grünmais, Maissilage, Maiskornsilage, CCM Sojaextraktionsschrot (Rohprotein) Auf der Homepage des Futtermittellabors Rosenau sind Probenbegleitscheine und eine Tarifliste online unter verfügbar. Nachfolgend werden Orientierungsbereiche für gute Futterqualitäten aufgelistet. Sie bieten eine Orientierungshilfe für die Einordnung der Werte des eigenen Befundes. Grundfutteranalysen verstehen 3/8
4 Grassilage und Kleegrassilage Parameter 1. Aufwuchs Folgeaufwüchse Einheit Nährstoffe Trockenmasse TM g/kg FM Rohprotein XP > 140 > 160 g/kg TM Faserkohlenhydrate NDF g/kg TM Lignozellulose ADF g/kg TM Lignin ADL < 40 < 50 g/kg TM Rohfaser XF g/kg TM Zucker XZ > 20 > 20 g/kg TM Rohasche XA < 100 < 110 g/kg TM Umsetzbare Energie ME > 10,0 > 9,8 MJ/kg TM Nettoenergie-Laktation NEL > 6,0 > 5,8 MJ/kg TM Mineralstoffe Calcium Ca > 6,0 > 8,0 g/kg TM Phosphor P > 3,2 > 3,5 g/kg TM Magnesium Mg > 2,0 > 3,0 g/kg TM Kalium K < 30 < 30 g/kg TM Natrium Na > 0,4 > 0,5 g/kg TM Eisen Fe < 600 < 800 mg/kg TM Mangan Mn > 70 > 90 mg/kg TM Zink Zn > 30 > 40 mg/kg TM Kupfer Cu > 8 > 9 mg/kg TM Gärverlauf Milchsäure MS > 75 > 75 % Essigsäure ES g/kg TM Buttersäure BS < 3 < 3 g/kg TM Ammoniakstickstoff NH 3 -N < 8 < 8 % Grundfutteranalysen verstehen 4/8
5 Maissilage Parameter Maissilage Einheit Nährstoffe Trockenmasse TM g/kg FM Rohprotein XP > 70 g/kg TM Faserkohlenhydrate NDF g/kg TM Lignozellulose ADF g/kg TM Lignin ADL < 30 g/kg TM Rohfaser XF g/kg TM Stärke XS > 320 g/kg TM Rohasche XA < 40 g/kg TM Umsetzbare Energie ME > 10,8 MJ/kg TM Nettoenergie-Laktation NEL > 6,5 MJ/kg TM Mineralstoffe Calcium Ca 1,8 2,4 g/kg TM Phosphor P 1,6 2,2 g/kg TM Magnesium Mg 1,0 1,8 g/kg TM Kalium K 7 11 g/kg TM Natrium Na > 0,05 g/kg TM Eisen Fe < 250 mg/kg TM Mangan Mn mg/kg TM Zink Zn mg/kg TM Kupfer Cu 3 6 mg/kg TM Gärverlauf Milchsäure MS > 80 % Essigsäure ES g/kg TM Buttersäure BS < 1 g/kg TM Ethanol EtOH < 3 g/kg TM Ammoniakstickstoff NH 3 -N < 8 % Grundfutteranalysen verstehen 5/8
6 Belüftungsheu und Bodenheu Parameter Belüftungsheu 1. Aufwuchs Folgeaufwüchse Bodenheu 1. Aufwuchs Folgeaufwüchse Einheit Nährstoffe Trockenmasse TM > 870 > 870 > 870 > 870 g Rohprotein XP > 120 > 140 > 100 > 130 g NDF g Lignozellulose ADF g Lignin ADL < 40 < 50 < 50 < 45 g Rohfaser XF g Zucker XZ g Rohasche XA < 90 < 110 < 80 < 100 g Umsetzbare Energie Faserkohlenhydrate Nettoenergie- Laktation ME > 10,0 > 9,7 > 9,3 > 9,4 MJ NEL > 6,0 > 5,7 > 5,4 > 5,5 MJ Mineralstoffe Calcium Ca > 5,0 > 6,0 > 5,0 > 6,0 g Phosphor P > 3,0 > 3,3 > 2,5 > 2,8 g Magnesium Mg > 2,5 > 3,0 > 2,5 > 3,0 g Kalium K g Natrium Na > 0,3 > 0,4 > 0,3 > 0,4 g Eisen Fe < 600 < 800 < 600 < 800 mg Mangan Mn > 70 > 90 > 70 > 90 mg Zink Zn > 30 > 40 > 30 > 40 mg Kupfer Cu > 8 > 9 > 8 > 9 mg Grundfutteranalysen verstehen 6/8
7 Grundfutteranalysen verstehen 7/8
8 RINDERFÜTTERUNG RATIONSBERECHNUNG Die Berater der Landwirtschaftskammer bieten eine objektive und unabhängige Rationsberechnung damit das Grundfutter bestmöglich verwertet und das Kraftfutter effizient eingesetzt werden kann. MILCHVIEH FÜTTERUNGS-CHECK Bei einer vor Ort Beratung werden Fütterung, Fruchtbarkeit und Stoffwechselsituation der Milchviehherde analysiert. Eine detaillierte Rationsgestaltung mit entsprechenden Beratungsempfehlungen wird erstellt und unterstützt Sie bei der täglichen Arbeit. BERATUNGSPAKET FÜTTERUNG Auf Basis des Milchvieh-Fütterungs-Checks wird eine Beratungsvereinbarung für ein Jahr mit bis zu drei Betriebsbesuchen abgeschlossen. Grundfutteranalysen verstehen 8/8
Rationsvorschläge Milchvieh
 Rationsvorschläge Milchvieh Leistungsgerechte Kraftfutterergänzung Beratungsstelle Rinderproduktion OÖ. Stand: 206-0 Inhaltsverzeichnis Rationen berechnen... 3 00 % Grassilage und Heu... 4 ⅔ Grassilage,
Rationsvorschläge Milchvieh Leistungsgerechte Kraftfutterergänzung Beratungsstelle Rinderproduktion OÖ. Stand: 206-0 Inhaltsverzeichnis Rationen berechnen... 3 00 % Grassilage und Heu... 4 ⅔ Grassilage,
Bedarfsnormen für Milchvieh
 Bedarfsnormen für Milchvieh Nährstoffe, Mineralstoffe, Vitamine Beratungsstelle Rinderproduktion OÖ. Stand: 2016- Inhaltsverzeichnis Energie (NEL) und nutzbares Rohprotein (nxp)... 2 Erhaltungsbedarf...
Bedarfsnormen für Milchvieh Nährstoffe, Mineralstoffe, Vitamine Beratungsstelle Rinderproduktion OÖ. Stand: 2016- Inhaltsverzeichnis Energie (NEL) und nutzbares Rohprotein (nxp)... 2 Erhaltungsbedarf...
Grundfutter hat höchste Bedeutung in der Milchviehfütterung
 Grundfutter hat höchste Bedeutung in der Milchviehfütterung Eigenbestandsbesamertagung Ing. Mag. (FH) Peter Frank Fachbereich Tier, Feld, Bio Übersicht Grassilage und Heuqualität in Tirol 2015 Wo liegen
Grundfutter hat höchste Bedeutung in der Milchviehfütterung Eigenbestandsbesamertagung Ing. Mag. (FH) Peter Frank Fachbereich Tier, Feld, Bio Übersicht Grassilage und Heuqualität in Tirol 2015 Wo liegen
Prüfung von Rapsextraktionsschrot
 Prüfung von Rapsextraktionsschrot In den DLG-Futterwerttabellen für Wiederkäuer werden beim Rapsextraktionsschrot unterschiedliche Qualitäten aufgeführt. Unterschieden wird in 00-Qualitäten und in alte
Prüfung von Rapsextraktionsschrot In den DLG-Futterwerttabellen für Wiederkäuer werden beim Rapsextraktionsschrot unterschiedliche Qualitäten aufgeführt. Unterschieden wird in 00-Qualitäten und in alte
Futterwert-Untersuchung Grassilage Mineralstoffe 1 Schnitt
 Futterwert-Untersuchung Grassilage Mineralstoffe 1 Schnitt Binnenhaven 5 NL - 6709 PD Wageningen T Probenahme: Jan van Leeuwen: T Kundenservice: +49 (0)700 00 00 2544 F +31 (0)88 876 1011 E [email protected]
Futterwert-Untersuchung Grassilage Mineralstoffe 1 Schnitt Binnenhaven 5 NL - 6709 PD Wageningen T Probenahme: Jan van Leeuwen: T Kundenservice: +49 (0)700 00 00 2544 F +31 (0)88 876 1011 E [email protected]
Sinn und Nutzen von Futtermitteluntersuchungen Analysemöglichkeiten im Futtermittellabor Rosenau der Landwirtschaftskammer Niederösterreich
 Sinn und Nutzen von Futtermitteluntersuchungen Analysemöglichkeiten im Futtermittellabor Rosenau der Landwirtschaftskammer Niederösterreich Laborleiter DI Gerald Stögmüller Inhalt Herausforderungen in
Sinn und Nutzen von Futtermitteluntersuchungen Analysemöglichkeiten im Futtermittellabor Rosenau der Landwirtschaftskammer Niederösterreich Laborleiter DI Gerald Stögmüller Inhalt Herausforderungen in
Kleegrassilagen in Ökobetrieben Futterwert, Mineralstoffgehalt und Gärqualität
 Kleegrassilagen in Ökobetrieben Futterwert, Mineralstoffgehalt und Gärqualität Fragestellungen: Wie hoch sind die Mineralstoff- und Spurenelementgehalte? Welcher Futterwert und welche Gärqualität wurden
Kleegrassilagen in Ökobetrieben Futterwert, Mineralstoffgehalt und Gärqualität Fragestellungen: Wie hoch sind die Mineralstoff- und Spurenelementgehalte? Welcher Futterwert und welche Gärqualität wurden
Mineralstoffgehalte in Silagen Michael Egert LUFA Nord-West, Institut für Futtermittel, Oldenburg
 Mineralstoffgehalte in Silagen Michael Egert LUFA Nord-West, Institut für Futtermittel, Oldenburg Einleitung Die Grassilage ist neben der Maissilage das wichtigste Grundfutter in der Rindviehhaltung. Aus
Mineralstoffgehalte in Silagen Michael Egert LUFA Nord-West, Institut für Futtermittel, Oldenburg Einleitung Die Grassilage ist neben der Maissilage das wichtigste Grundfutter in der Rindviehhaltung. Aus
19. Alpenländisches Expertenforum. Auswirkungen unterschiedlicher Trocknungsverfahren auf die Raufutterqualität
 19. Alpenländisches Expertenforum Auswirkungen unterschiedlicher Trocknungsverfahren auf die Raufutterqualität Reinhard Resch LFZ-Institut Pflanzenbau und Kulturlandschaft Überblick Einleitung und Problemstellung
19. Alpenländisches Expertenforum Auswirkungen unterschiedlicher Trocknungsverfahren auf die Raufutterqualität Reinhard Resch LFZ-Institut Pflanzenbau und Kulturlandschaft Überblick Einleitung und Problemstellung
Die Futtermitteluntersuchung als Basis für eine leistungsgerechte Ration
 Lehr- und Forschungszentrum für Landwirtschaft Raumberg-Gumpenstein 5. Tierärztetagung 2012 73 78 ISBN: 978-3-902559-76-0 Franz Tiefenthaller 1* Einleitung Die möglichst optimale Versorgung landwirtschaftlicher
Lehr- und Forschungszentrum für Landwirtschaft Raumberg-Gumpenstein 5. Tierärztetagung 2012 73 78 ISBN: 978-3-902559-76-0 Franz Tiefenthaller 1* Einleitung Die möglichst optimale Versorgung landwirtschaftlicher
14. Raminer Futterbautag 9. Oktober 2013 Passende Silagen gezielt erzeugen
 14. Raminer Futterbautag 9. Oktober 2013 Bernd Losand Mittelwerte sind nur Mittelwerte auch in diesem Jahr! - Untersuchungsergebnisse der LUFA Rostock - Kennwert Einheit 2012 2013 1 S. 2012 1.Schnitt von
14. Raminer Futterbautag 9. Oktober 2013 Bernd Losand Mittelwerte sind nur Mittelwerte auch in diesem Jahr! - Untersuchungsergebnisse der LUFA Rostock - Kennwert Einheit 2012 2013 1 S. 2012 1.Schnitt von
,1 26,9 3, ,1 28,5 3, ,3 33,2 3, ,6 33,1 3,6 Mittelwert ,8 30,4 3,5
 Bestimmung der Verdaulichkeit von Mischrationen bei variierendem Ernährungsniveau 1 Tabelle 1: Zusammensetzung der TMR Komponenten Anteil, % bezogen auf TM Grassilage, 7B, 2004 45,0 Maissilage 2S, 2004
Bestimmung der Verdaulichkeit von Mischrationen bei variierendem Ernährungsniveau 1 Tabelle 1: Zusammensetzung der TMR Komponenten Anteil, % bezogen auf TM Grassilage, 7B, 2004 45,0 Maissilage 2S, 2004
Tabelle 1: Erhaltungsbedarf und Leistungsbedarf der Milchkühe. Lebendgewicht Rohproteinbedarf je Tag Energiebedarf je Tag
 Mit MILLIWIN eine erfolgreiche Milchviehfütterung möglich machen Für eine erfolgreiche Milchviehfütterung sind Rationsberechnungen die Basis, um langfristig hohe Milchleistungen bei Aufrechterhaltung von
Mit MILLIWIN eine erfolgreiche Milchviehfütterung möglich machen Für eine erfolgreiche Milchviehfütterung sind Rationsberechnungen die Basis, um langfristig hohe Milchleistungen bei Aufrechterhaltung von
Erst testen - dann füttern
 Erst testen - dann füttern Wirtschaftlicher füttern auf der Basis von Grundfutteranalysen Warum überhaupt Grundfutteranalysen? Niedrige Milchpreise zwingen den Betriebsleiter dazu, Grund- und Kraftfutter
Erst testen - dann füttern Wirtschaftlicher füttern auf der Basis von Grundfutteranalysen Warum überhaupt Grundfutteranalysen? Niedrige Milchpreise zwingen den Betriebsleiter dazu, Grund- und Kraftfutter
35,9 34,4 34,9 35, Rohprotein 7,8 (% der T) (4,2-13,8) 7,3 8,0 7,7 8,1 < 9 nxp 135 (g/kg T) ( )
 Auswertung zu den Maissilagequalitäten 2015 Maissilage stellt in vielen rindviehhaltenden Betrieben neben Grassilage das wichtigste Grundfutter für die Fütterung dar. Allgemein weist Maissilage einen höheren
Auswertung zu den Maissilagequalitäten 2015 Maissilage stellt in vielen rindviehhaltenden Betrieben neben Grassilage das wichtigste Grundfutter für die Fütterung dar. Allgemein weist Maissilage einen höheren
Bayerische Landesanstalt für Landwirtschaft Institut für Tierernährung und Futterwirtschaft
 Bayerische Landesanstalt für Landwirtschaft Institut für Tierernährung und Futterwirtschaft 15.07.2015 Versuchsbericht über die Prüfung zum Einfluss der Umgebungstemperatur auf die Gärqualität und aerobe
Bayerische Landesanstalt für Landwirtschaft Institut für Tierernährung und Futterwirtschaft 15.07.2015 Versuchsbericht über die Prüfung zum Einfluss der Umgebungstemperatur auf die Gärqualität und aerobe
Geprüfte Milchleistungsfutter
 Riswicker Ergebnisse: Energetische Futterwertprüfung, Jahresüberblick 2011 1 Übersicht 1: Geprüfte Futter in 2011 Anzahl Handelsfuttermittel Mischfutter für Kühe (52) und Schafe (4) 56 Futter aus RiswickerVersuchen
Riswicker Ergebnisse: Energetische Futterwertprüfung, Jahresüberblick 2011 1 Übersicht 1: Geprüfte Futter in 2011 Anzahl Handelsfuttermittel Mischfutter für Kühe (52) und Schafe (4) 56 Futter aus RiswickerVersuchen
Projekt Futterwert von High Sugar Gras Laufzeit: Martin Pries, Clara Berendonk, Klaus Hünting, Silke Beintmann, Claudia Verhülsdonk
 Projekt Futterwert von High Sugar Gras Laufzeit: 2007-2012 Martin Pries, Clara Berendonk, Klaus Hünting, Silke Beintmann, Claudia Verhülsdonk Fokus Riswick 2011 Hypothese: High Sugar Gras ist wegen des
Projekt Futterwert von High Sugar Gras Laufzeit: 2007-2012 Martin Pries, Clara Berendonk, Klaus Hünting, Silke Beintmann, Claudia Verhülsdonk Fokus Riswick 2011 Hypothese: High Sugar Gras ist wegen des
Thüringer Landesanstalt. für Landwirtschaft, Standpunkt. zur. Silagequalität. Thüringer Ministerium. Naturschutz und Umwelt
 Thüringer Landesanstalt für Landwirtschaft Standpunkt zur Silagequalität Thüringer Ministerium für Landwirtschaft, Naturschutz und Umwelt Besuchen Sie uns auch im Internet: www.tll.de/ainfo Impressum 1.
Thüringer Landesanstalt für Landwirtschaft Standpunkt zur Silagequalität Thüringer Ministerium für Landwirtschaft, Naturschutz und Umwelt Besuchen Sie uns auch im Internet: www.tll.de/ainfo Impressum 1.
Kälber TMR. Herstellung, Vorteile, Beispiele. Referat Fütterung/Beratungsstelle Rinderproduktion Stand:
 Kälber TMR Herstellung, Vorteile, Beispiele Referat Fütterung/Beratungsstelle Rinderproduktion Stand: 201610 Inhaltsverzeichnis Was ist eine KälberTMR?... 3 Vorteile... 3 Nachteile... Herstellung... Mischungsbeispiele...
Kälber TMR Herstellung, Vorteile, Beispiele Referat Fütterung/Beratungsstelle Rinderproduktion Stand: 201610 Inhaltsverzeichnis Was ist eine KälberTMR?... 3 Vorteile... 3 Nachteile... Herstellung... Mischungsbeispiele...
Fütterung von Hochleistungskühen unter ökologischen Bedingungen. Silke Dunkel Thüringer Landesanstalt für Landwirtschaft
 Fütterung von Hochleistungskühen unter ökologischen Bedingungen Silke Dunkel Thüringer Landesanstalt für Landwirtschaft ÖKO-Verordnung Verordnung (EWG) NR. 2092/91 des Rates vom 2. Juni 1991 über den ökologischen
Fütterung von Hochleistungskühen unter ökologischen Bedingungen Silke Dunkel Thüringer Landesanstalt für Landwirtschaft ÖKO-Verordnung Verordnung (EWG) NR. 2092/91 des Rates vom 2. Juni 1991 über den ökologischen
Empfohlene Nährstoffgehalte: Parameter Zielwerte Bedeutung Trockenmasse: >870 g/kg Futter (= 87%) ausreichende Trocknung für die Lagerfähigkeit
 Artikel Heuqualitäten in der Praxis St. Pölten, 9. Oktober 2017 Pferde werden überwiegend mit Heu gefüttert. Neben dem Nährstoffgehalt hat besonders auch die Futterhygiene eine besondere Bedeutung. Wie
Artikel Heuqualitäten in der Praxis St. Pölten, 9. Oktober 2017 Pferde werden überwiegend mit Heu gefüttert. Neben dem Nährstoffgehalt hat besonders auch die Futterhygiene eine besondere Bedeutung. Wie
Maissilage 2017 Energie aus dem Grobfutter!
 Maissilage 2017 Energie aus dem Grobfutter! Die Auswertung der ersten 1200 am LKV-Labor in Grub untersuchten Proben der Maissilage 2017 zeigt hohe Fett-, Zucker- und Stärkegehalte. Die diesjährige Maissilage
Maissilage 2017 Energie aus dem Grobfutter! Die Auswertung der ersten 1200 am LKV-Labor in Grub untersuchten Proben der Maissilage 2017 zeigt hohe Fett-, Zucker- und Stärkegehalte. Die diesjährige Maissilage
Untersuchungsbericht zur energetischen Grundfutterbewertung in Thüringen mit neuen Schätzgleichungen
 Thüringer Landesanstalt für Landwirtschaft Untersuchungsbericht zur energetischen Grundfutterbewertung in Thüringen mit neuen Schätzgleichungen Thüringer Ministerium für Landwirtschaft, Naturschutz und
Thüringer Landesanstalt für Landwirtschaft Untersuchungsbericht zur energetischen Grundfutterbewertung in Thüringen mit neuen Schätzgleichungen Thüringer Ministerium für Landwirtschaft, Naturschutz und
8 Sicherheit der Analysenqualität bei Gras- und Maissilage
 8 Sicherheit der Analysenqualität bei Gras- und Maissilage H. Spiekers 1, M. Pries 2, T. Ettle 1, J. Danier 3, H. Schenkel 4 1 Bayerische Landesanstalt für Landwirtschaft, Institut für Tierernährung und
8 Sicherheit der Analysenqualität bei Gras- und Maissilage H. Spiekers 1, M. Pries 2, T. Ettle 1, J. Danier 3, H. Schenkel 4 1 Bayerische Landesanstalt für Landwirtschaft, Institut für Tierernährung und
Auswertung zu den Grassilagequalitäten 2015
 Auswertung zu den Grassilagequalitäten 2015 Die Grassilage ist neben der Maissilage das wichtigste Grundfutter in der Rindviehhaltung. Aus ökonomischen und physiologischen Gründen wird eine möglichst hohe
Auswertung zu den Grassilagequalitäten 2015 Die Grassilage ist neben der Maissilage das wichtigste Grundfutter in der Rindviehhaltung. Aus ökonomischen und physiologischen Gründen wird eine möglichst hohe
2012 mit guter Grassilage Kraftfutter sparen
 1 2012 mit guter Grassilage Kraftfutter sparen Auch 2012 wurden wieder gute Grassilage-Qualitäten erreicht; allerdings nicht in allen Teilen Bayerns. Rund 2300 Proben aus dem ersten und 2100 Proben aus
1 2012 mit guter Grassilage Kraftfutter sparen Auch 2012 wurden wieder gute Grassilage-Qualitäten erreicht; allerdings nicht in allen Teilen Bayerns. Rund 2300 Proben aus dem ersten und 2100 Proben aus
Maissilage 2009 geht s noch besser? Die Maissilageernte 2009 zeigte eine gute Qualität. Bei sehr hoch gewachsenen Beständen führte dies aber
 Maissilage 2009 geht s noch besser? Die Maissilageernte 2009 zeigte eine gute Qualität. Bei sehr hoch gewachsenen Beständen führte dies aber teilweise zu mehr Masse auf Kosten von Energie. Der Silomais
Maissilage 2009 geht s noch besser? Die Maissilageernte 2009 zeigte eine gute Qualität. Bei sehr hoch gewachsenen Beständen führte dies aber teilweise zu mehr Masse auf Kosten von Energie. Der Silomais
Einfluss von Zeolith und einem Milchsäurebakterien- Präparat auf Futteraufnahme und Milchleistung sowie Nährstoffverdaulichkeit von Milchkühen
 Einfluss von Zeolith und einem Milchsäurebakterien- Präparat auf Futteraufnahme und Milchleistung sowie Nährstoffverdaulichkeit von Milchkühen DI M. Urdl, DI A. Patz LFZ Raumberg-Gumpenstein 40. Viehwirtschaftliche
Einfluss von Zeolith und einem Milchsäurebakterien- Präparat auf Futteraufnahme und Milchleistung sowie Nährstoffverdaulichkeit von Milchkühen DI M. Urdl, DI A. Patz LFZ Raumberg-Gumpenstein 40. Viehwirtschaftliche
Milchkuhfütterung ohne Sojaextraktionsschrot UNION ZUR FÖRDERUNG VON OEL- UND PROTEINPFLANZEN E.V.
 UNION ZUR FÖRDERUNG VON OEL- UND PROTEINPFLANZEN E.V. Milchkuhfütterung ohne Sojaextraktionsschrot Thomas Bonsels, Landesbetrieb Landwirtschaft Hessen, Kassel Dr. Jürgen Weiß, Kassel 2 UFOP Milchkuhfütterung
UNION ZUR FÖRDERUNG VON OEL- UND PROTEINPFLANZEN E.V. Milchkuhfütterung ohne Sojaextraktionsschrot Thomas Bonsels, Landesbetrieb Landwirtschaft Hessen, Kassel Dr. Jürgen Weiß, Kassel 2 UFOP Milchkuhfütterung
Beurteilung von Futterqualitätskenngrößen und deren Verbesserungsansätze Gliederung:
 Beurteilung von Futterqualitätskenngrößen und deren Verbesserungsansätze Gliederung: Futterwert 1 Trockenmassegehalt o Grassilage. 2 o Maissilage. 3 Rohproteingehalt o Grassilage. 4 o Maissilage. 4 Rohfasergehalt
Beurteilung von Futterqualitätskenngrößen und deren Verbesserungsansätze Gliederung: Futterwert 1 Trockenmassegehalt o Grassilage. 2 o Maissilage. 3 Rohproteingehalt o Grassilage. 4 o Maissilage. 4 Rohfasergehalt
Wie füttere ich meine Herde richtig? Eigene Futtermittel gezielt einsetzen. Ulrike Koch, Bioland Beratung Harburg,
 Wie füttere ich meine Herde richtig? Eigene Futtermittel gezielt einsetzen Harburg, 20.2.2018 1 Gliederung Grundlagen der Milchviehfütterung und Pansenfunktion Grundfutterqualität Heimische Energieträger
Wie füttere ich meine Herde richtig? Eigene Futtermittel gezielt einsetzen Harburg, 20.2.2018 1 Gliederung Grundlagen der Milchviehfütterung und Pansenfunktion Grundfutterqualität Heimische Energieträger
Verwertung von Getreideschlempen und Ölkuchen beim Wiederkäuer
 Verwertung von Getreideschlempen und Ölkuchen beim Wiederkäuer Wintertagung 16.02.2007 L. Gruber / M. Urdl Institut für Nutztierforschung Einleitung Verfügbarkeit (ab 2007): 170.000 t Futtermittel aus
Verwertung von Getreideschlempen und Ölkuchen beim Wiederkäuer Wintertagung 16.02.2007 L. Gruber / M. Urdl Institut für Nutztierforschung Einleitung Verfügbarkeit (ab 2007): 170.000 t Futtermittel aus
Schätzung des Energiegehaltes in Grasprodukten Bericht zum Stand neuer Ableitungen
 Schätzung des Energiegehaltes in Grasprodukten Bericht zum Stand neuer Ableitungen B. Losand 1, M. Pries 2, Annette Menke 2, E. Tholen 3,L. Gruber 4, F. Hertwig 5, T. Jilg 6, H. Kluth 7, H. Spiekers 8,
Schätzung des Energiegehaltes in Grasprodukten Bericht zum Stand neuer Ableitungen B. Losand 1, M. Pries 2, Annette Menke 2, E. Tholen 3,L. Gruber 4, F. Hertwig 5, T. Jilg 6, H. Kluth 7, H. Spiekers 8,
Grünprodukte 2011 - Luzerne bringt gute Eiweißergebnisse
 1 Grünprodukte 2011 - Luzerne bringt gute Eiweißergebnisse Im Erntejahr 2011 wurden bis Ende Oktober aus Bayern rund 280 Proben von Kleegras-, Luzerne-, Luzernegrassilagen, Heu- und Graskobs zur Untersuchung
1 Grünprodukte 2011 - Luzerne bringt gute Eiweißergebnisse Im Erntejahr 2011 wurden bis Ende Oktober aus Bayern rund 280 Proben von Kleegras-, Luzerne-, Luzernegrassilagen, Heu- und Graskobs zur Untersuchung
Grobfutterqualität: Bedeutung, Anforderungen, Folgerungen
 DLG Grünlandtag 2007; Arnstadt Grobfutterqualität: t: Bedeutung, Anforderungen, Folgerungen Dr. Martin Pries Referent für Wiederkäuerfütterung Zukaufspreise, lose frei Hof ab 3 t, in Euro/t, Region Westfalen-Lippe
DLG Grünlandtag 2007; Arnstadt Grobfutterqualität: t: Bedeutung, Anforderungen, Folgerungen Dr. Martin Pries Referent für Wiederkäuerfütterung Zukaufspreise, lose frei Hof ab 3 t, in Euro/t, Region Westfalen-Lippe
Handelsfuttermittel für Schafe/Ziegen 2016
 Handelsfuttermittel für Schafe/Ziegen 2016 Fertigfutter, Ergänzungsfutter, Mineralfutter Abteilung Tierproduktion/Referat Fütterung Stand: 2017-01 Inhaltsverzeichnis Abkürzungen... 3 Einleitung... 4 Aktualität...
Handelsfuttermittel für Schafe/Ziegen 2016 Fertigfutter, Ergänzungsfutter, Mineralfutter Abteilung Tierproduktion/Referat Fütterung Stand: 2017-01 Inhaltsverzeichnis Abkürzungen... 3 Einleitung... 4 Aktualität...
08. Oktober 2014, 7. Thüringisch-Sächsisches Kolloquium zur Fütterung. Stefanie Muche und Dr. Wolfram Richardt
 08. Oktober 2014, 7. Thüringisch-Sächsisches Kolloquium zur Fütterung Stefanie Muche und Dr. Wolfram Richardt 1. Kennzahlen der Futterqualität 2. Fütterungsversuche 3. Darstellung der in vitro- Methode
08. Oktober 2014, 7. Thüringisch-Sächsisches Kolloquium zur Fütterung Stefanie Muche und Dr. Wolfram Richardt 1. Kennzahlen der Futterqualität 2. Fütterungsversuche 3. Darstellung der in vitro- Methode
Extrudierte Leinsaat in der Milchviehfütterung. Fokus Riswick
 Extrudierte Leinsaat in der Milchviehfütterung Fokus Riswick 2011 1 Zur Erinnerung: Einteilung der Fette GFS und UFS gesättigte Fettsäuren Bsp: Palmöl ω3 ω3 ω3 ω3 ω3ω3 EUFS ungesättigte Fettsäuren Einfach-ungesättigt
Extrudierte Leinsaat in der Milchviehfütterung Fokus Riswick 2011 1 Zur Erinnerung: Einteilung der Fette GFS und UFS gesättigte Fettsäuren Bsp: Palmöl ω3 ω3 ω3 ω3 ω3ω3 EUFS ungesättigte Fettsäuren Einfach-ungesättigt
Grundfuttersituation in den Schafherden des Kontroll- und Beratungsringes Lämmermast
 Grundfuttersituation in den Schafherden des Kontroll- und Beratungsringes Lämmermast Gliederung Übersicht zum Beratungsbereich Problembereiche und Grundfuttersituation Auswertung Grundfutteranalysen Ökonomische
Grundfuttersituation in den Schafherden des Kontroll- und Beratungsringes Lämmermast Gliederung Übersicht zum Beratungsbereich Problembereiche und Grundfuttersituation Auswertung Grundfutteranalysen Ökonomische
Praktische Beurteilung von Heu und Silage
 Schulung Grundfutterqualität Jagdzentrum Stegenwald, Tenneck, 29. März 2011 Praktische Beurteilung von Heu und Silage Ing. Reinhard Resch Institut für Pflanzenbau und Kulturlandschaft Grundfutter bewerten
Schulung Grundfutterqualität Jagdzentrum Stegenwald, Tenneck, 29. März 2011 Praktische Beurteilung von Heu und Silage Ing. Reinhard Resch Institut für Pflanzenbau und Kulturlandschaft Grundfutter bewerten
Mögliche Rationsbeispiele für Milchkühe
 Mögliche Rationsbeispiele für kühe R. Maierhofer, M. Moosmeyer, A. Obermaier In den nachfolgenden Seiten wurden 16 verschiedene Kraftfuttermischungen konzipiert. Sie reichen von einfachen bis zu sehr hochwertigen
Mögliche Rationsbeispiele für kühe R. Maierhofer, M. Moosmeyer, A. Obermaier In den nachfolgenden Seiten wurden 16 verschiedene Kraftfuttermischungen konzipiert. Sie reichen von einfachen bis zu sehr hochwertigen
Ausgeklügeltes Fütterungs- und Herdenmanagement auf dem Low- Input Milchviehbetrieb Andreas Schori, Meliofeed AG
 Ausgeklügeltes Fütterungs- und Herdenmanagement auf dem Low- Input Milchviehbetrieb Andreas Schori, Meliofeed AG 12.11.2013 1 Themen Low-Input-Milchbetriebe 1. Low-Input Betriebe in der Schweiz 2. Grassilage-
Ausgeklügeltes Fütterungs- und Herdenmanagement auf dem Low- Input Milchviehbetrieb Andreas Schori, Meliofeed AG 12.11.2013 1 Themen Low-Input-Milchbetriebe 1. Low-Input Betriebe in der Schweiz 2. Grassilage-
INHALT. Einleitung 4 Begriffe und Abkürzungen 6 Kosten je kg Milch 8 Leis tungsgerechte Fütterung Schlüssel zum Erfolg 10
 Einleitung 4 Begriffe und Abkürzungen 6 Kosten je kg Milch 8 Leis tungsgerechte Fütterung Schlüssel zum Erfolg 10 Futterbedarf ermitteln 14 Futterqualität optimieren 16 Hochwertiges Grobfutter erzeugen!
Einleitung 4 Begriffe und Abkürzungen 6 Kosten je kg Milch 8 Leis tungsgerechte Fütterung Schlüssel zum Erfolg 10 Futterbedarf ermitteln 14 Futterqualität optimieren 16 Hochwertiges Grobfutter erzeugen!
Mineralstoffgehalte der wichtigsten Futtermittel auf dem Milchviehbetrieb
 Eidgenössisches Departement für Wirtschaft, Bildung und Forschung WBF Agroscope Mineralstoffgehalte der wichtigsten Futtermittel auf dem Milchviehbetrieb Patrick Schlegel Zürich, 24.11.2015 Wieviel ist
Eidgenössisches Departement für Wirtschaft, Bildung und Forschung WBF Agroscope Mineralstoffgehalte der wichtigsten Futtermittel auf dem Milchviehbetrieb Patrick Schlegel Zürich, 24.11.2015 Wieviel ist
Wie und woran erkennen wir Futterqualitäten beim Heu
 6. Österreichische Pferdefachtagung Wie und woran erkennen wir Futterqualitäten beim Heu von HBLFA Raumberg-Gumpenstein Aigen/Ennstal, 04. März 2017 raumberg-gumpenstein.at Grünlandflächen in Österreich
6. Österreichische Pferdefachtagung Wie und woran erkennen wir Futterqualitäten beim Heu von HBLFA Raumberg-Gumpenstein Aigen/Ennstal, 04. März 2017 raumberg-gumpenstein.at Grünlandflächen in Österreich
Futterqualität beurteilen - Reserven auf dem Grünland erschließen. 10. Seminar Futterproduktion
 10. Seminar Futterproduktion Futterqualität beurteilen - Reserven auf dem Grünland erschließen Dr. Heidi Jänicke Institut für Tierproduktion Dummerstorf 2. März 2016 Futterqualität - Merkmalskomplex Sensorik
10. Seminar Futterproduktion Futterqualität beurteilen - Reserven auf dem Grünland erschließen Dr. Heidi Jänicke Institut für Tierproduktion Dummerstorf 2. März 2016 Futterqualität - Merkmalskomplex Sensorik
Trockenschlempe (DDGS) in der Milchviehfütterung ActiProt
 Trockenschlempe (DDGS) in der Milchviehfütterun ActiProt DI Gerald Stömüller (LK NÖ) DI Franz Tiefenthaller (LK OÖ) DI Marc Urdl (LFZ Raumber-Gumpenstein) DI Günther Wiedner (LK NÖ) DI Karl Wurm (LK Stmk)
Trockenschlempe (DDGS) in der Milchviehfütterun ActiProt DI Gerald Stömüller (LK NÖ) DI Franz Tiefenthaller (LK OÖ) DI Marc Urdl (LFZ Raumber-Gumpenstein) DI Günther Wiedner (LK NÖ) DI Karl Wurm (LK Stmk)
Effiziente Eiweißfütterung bei Rindern
 Effiziente Eiweißfütterung bei Rindern Andreaas Steinwidder, Bio-Institut LFZ Raumberg-Gumpenstein Andreas Steinwidder Bio-Institut www.raumberg-gumpenstein.at 1 2 3 U 4 V 5 V 6 V 7 V 8 V 9 V 10 V 11 V
Effiziente Eiweißfütterung bei Rindern Andreaas Steinwidder, Bio-Institut LFZ Raumberg-Gumpenstein Andreas Steinwidder Bio-Institut www.raumberg-gumpenstein.at 1 2 3 U 4 V 5 V 6 V 7 V 8 V 9 V 10 V 11 V
2. Österreichische Pferdefachtagung Aigen im Ennstal, 23. Februar 2013
 2. Österreichische Pferdefachtagung Aigen im Ennstal, 23. Februar 2013 Die Bewertungskriterien für Heu, Silage, Gärheu und Stroh Wie gehe ich in der Beurteilung vor? Ing. Reinhard Resch Institut für Pflanzenbau
2. Österreichische Pferdefachtagung Aigen im Ennstal, 23. Februar 2013 Die Bewertungskriterien für Heu, Silage, Gärheu und Stroh Wie gehe ich in der Beurteilung vor? Ing. Reinhard Resch Institut für Pflanzenbau
Rohfaser ADF org Zucker ME NEL Ca P % g/kg TM MJ/kg TM g/kg TM MW 91,3 88,7 106,7-3,0 298,7 370,0 95,5 8,5 4,9 6,8 1,9
 Landwirtschaftliches Zentrum für Rinderhaltung, Grünlandwirtschaft, Milchwirtschaft, Wild und Fischerei Baden-Württemberg (LAZBW) - Rinderhaltung Aulendorf- Fütterung von Hochleistungskühen mit FFH-Grünland
Landwirtschaftliches Zentrum für Rinderhaltung, Grünlandwirtschaft, Milchwirtschaft, Wild und Fischerei Baden-Württemberg (LAZBW) - Rinderhaltung Aulendorf- Fütterung von Hochleistungskühen mit FFH-Grünland
Sensorische Bewertung von Silage und Heu. Ing. Reinhard Resch. Sensorik-Seminar Grundfutter. Institut für Pflanzenbau und Kulturlandschaft
 Sensorik-Seminar Grundfutter Sensorische Bewertung von Silage und Heu Ing. Reinhard Resch Institut für Pflanzenbau und Kulturlandschaft Überblick Einführung Grundfutter-Sensorik Bestimmung Vegetationsstadium
Sensorik-Seminar Grundfutter Sensorische Bewertung von Silage und Heu Ing. Reinhard Resch Institut für Pflanzenbau und Kulturlandschaft Überblick Einführung Grundfutter-Sensorik Bestimmung Vegetationsstadium
Höchste Grundfutterqualität ist kein Kinderspiel jedoch lohnenswert! Inhalt
 Höchste Grundfutterqualität ist kein Kinderspiel jedoch lohnenswert! BLGG AgroXpertus Karen Oerlemans Inhalt BLGG AgroXpertus Proteinbeurteilung Zellwände Energiebeurteilung Silagemanager 1 BLGG AgroXpertus
Höchste Grundfutterqualität ist kein Kinderspiel jedoch lohnenswert! BLGG AgroXpertus Karen Oerlemans Inhalt BLGG AgroXpertus Proteinbeurteilung Zellwände Energiebeurteilung Silagemanager 1 BLGG AgroXpertus
Neue Bewertung von Gras- und Maisprodukten. Bernd Losand und Frank Hertwig
 Neue Bewertung von Gras- und Maisprodukten Bernd Losand und Frank Hertwig Warum neue Energieschätzgleichungen? 1 Grobfutter (Gras- und Silomais) Kritik an der Rohfaser als Beschreiber der Gerüstsubstanzen
Neue Bewertung von Gras- und Maisprodukten Bernd Losand und Frank Hertwig Warum neue Energieschätzgleichungen? 1 Grobfutter (Gras- und Silomais) Kritik an der Rohfaser als Beschreiber der Gerüstsubstanzen
Grünland- Futterquelle und/oder Pflegefall?
 Grünland- Futterquelle und/oder Pflegefall? mit betriebswirtschaftlichen Strategien auf die Zukunft ausrichten! 1 Fakten und Daten zur Flächenausstattung, -nutzung und -verwertung in Mecklenburg-Vorpommern
Grünland- Futterquelle und/oder Pflegefall? mit betriebswirtschaftlichen Strategien auf die Zukunft ausrichten! 1 Fakten und Daten zur Flächenausstattung, -nutzung und -verwertung in Mecklenburg-Vorpommern
Einsatz von Rapsprodukten in der MIlchviehfütterung
 Eurotier 2006 Forum Rind Einsatz von Rapsprodukten in der MIlchviehfütterung Prof. Dr. Gerhard Schwarting Klassifizierung der Proteine nach ihrer Funktion 1. Katalytische Proteine (Enzyme) - Oxydoreduktosen
Eurotier 2006 Forum Rind Einsatz von Rapsprodukten in der MIlchviehfütterung Prof. Dr. Gerhard Schwarting Klassifizierung der Proteine nach ihrer Funktion 1. Katalytische Proteine (Enzyme) - Oxydoreduktosen
Nähr- und Mineralstoffgehalt von Grundfuttermitteln in Österreich'
 (Aus der Nö. Landes-Landwirtschaftskammer, Abteilung Vieh- und Milchwirtschaft, Leiter Tierzuchtdirektor Dr. B. Laber, und der Bundesanstalt für alpenländische Landwirtschaft Gumpenstein, Leiter Hofrat
(Aus der Nö. Landes-Landwirtschaftskammer, Abteilung Vieh- und Milchwirtschaft, Leiter Tierzuchtdirektor Dr. B. Laber, und der Bundesanstalt für alpenländische Landwirtschaft Gumpenstein, Leiter Hofrat
Futterqualität und -verfügbarkeit für Schalenwild
 22. Österreichische Jägertagung Aigen i.e., 26. Februar 2016 Futterqualität und -verfügbarkeit für Schalenwild Reinhard Resch 1 und Franz Gahr 2 1 HBLFA-Institut für Pflanzenbau und Kulturlandschaft 2
22. Österreichische Jägertagung Aigen i.e., 26. Februar 2016 Futterqualität und -verfügbarkeit für Schalenwild Reinhard Resch 1 und Franz Gahr 2 1 HBLFA-Institut für Pflanzenbau und Kulturlandschaft 2
Wie viel Energie steckt im Rapskuchen?
 Wie viel Energie steckt im Rapskuchen? Im Landwirtschaftszentrum Haus Riswick wurde in Zusammenarbeit mit der Lehr- und Versuchsanstalt für Viehhaltung, Hofgut Neumühle und dem DLR Westpfalz eine Verdaulichkeitsmessung
Wie viel Energie steckt im Rapskuchen? Im Landwirtschaftszentrum Haus Riswick wurde in Zusammenarbeit mit der Lehr- und Versuchsanstalt für Viehhaltung, Hofgut Neumühle und dem DLR Westpfalz eine Verdaulichkeitsmessung
Rationsgestaltung zur Gesunderhaltung
 Kuh Nr./Name Rationsbezeichnung Laktationen Laktationstag Gewicht Milchleistung Übung 2 (tr. ="T") Fett Eiweiß s Gehaltswerte aus Ausgleichsfutterration = 18,6 421,0 36,7 86,4 906,8 32,4 194,3 0,4 NEL
Kuh Nr./Name Rationsbezeichnung Laktationen Laktationstag Gewicht Milchleistung Übung 2 (tr. ="T") Fett Eiweiß s Gehaltswerte aus Ausgleichsfutterration = 18,6 421,0 36,7 86,4 906,8 32,4 194,3 0,4 NEL
Einfluss der Konservierung auf die Qualität von Silage und Heu
 Seminar Wildfutterproduzenten Irdning, 16. März 2011 Einfluss der Konservierung auf die Qualität von Silage und Heu Ing. Reinhard Resch Institut für Pflanzenbau und Kulturlandschaft Q u a l i t ä t s g
Seminar Wildfutterproduzenten Irdning, 16. März 2011 Einfluss der Konservierung auf die Qualität von Silage und Heu Ing. Reinhard Resch Institut für Pflanzenbau und Kulturlandschaft Q u a l i t ä t s g
Mais in der Rinderfütterung
 Seite 1 von 10 Mais in der Rinderfütterung Aufgabe 1 Fügen Sie in der Darstellung zur Verdaulichkeit der Maispfl anze die folgenden, fehlenden Angaben an der richtigen Stelle ein: Restpflanze, Spindel,
Seite 1 von 10 Mais in der Rinderfütterung Aufgabe 1 Fügen Sie in der Darstellung zur Verdaulichkeit der Maispfl anze die folgenden, fehlenden Angaben an der richtigen Stelle ein: Restpflanze, Spindel,
Tipps für Herstellung von Top Silage, Silagebeurteilung, Häufige Probleme und deren Ursachen
 Eidgenössisches Departement für Wirtschaft, Bildung und Forschung WBF Agroscope Tipps für Herstellung von Top Silage, Silagebeurteilung, Häufige Probleme und deren Ursachen Ueli Wyss Silierstrategien für
Eidgenössisches Departement für Wirtschaft, Bildung und Forschung WBF Agroscope Tipps für Herstellung von Top Silage, Silagebeurteilung, Häufige Probleme und deren Ursachen Ueli Wyss Silierstrategien für
Erdige Futterverschmutzung ein unterschätztes Problem?
 Agritechnica Pflanzenbau Forum live Hannover, 11. November 2015 Erdige Futterverschmutzung ein unterschätztes Problem? HBLFA-Institut Pflanzenbau und Kulturlandschaft Auswirkungen von Futterverschmutzung
Agritechnica Pflanzenbau Forum live Hannover, 11. November 2015 Erdige Futterverschmutzung ein unterschätztes Problem? HBLFA-Institut Pflanzenbau und Kulturlandschaft Auswirkungen von Futterverschmutzung
Ansprüche der Milchviehhaltung an das Grundfutter vom Grünland
 22. Allgäuer Grünlandtag, 11.07.2008 Ansprüche der Milchviehhaltung an das Grundfutter vom Grünland Dr. Hubert Spiekers LfL, Institut für Tierernährung und Futterwirtschaft, Grub Grünland für Milchkühe
22. Allgäuer Grünlandtag, 11.07.2008 Ansprüche der Milchviehhaltung an das Grundfutter vom Grünland Dr. Hubert Spiekers LfL, Institut für Tierernährung und Futterwirtschaft, Grub Grünland für Milchkühe
Silohirseversuche 2015 und 2016
 Silohirseversuche 2 und 216 Versuchsziel: In den letzten Jahren verursachte der westliche Maiswurzelbohrer nicht nur bei Körnermais sondern in den kühleren Regionen der Steiermark auch beim Silomais zum
Silohirseversuche 2 und 216 Versuchsziel: In den letzten Jahren verursachte der westliche Maiswurzelbohrer nicht nur bei Körnermais sondern in den kühleren Regionen der Steiermark auch beim Silomais zum
Mikrobiologische Befunde verstehen
Mikrobiologische Befunde verstehen Futtermittel für landwirtschaftliche Nutztiere Referat Fütterung/Beratungsstellen Rinder- und Schweineproduktion Stand: 2016-10 Inhaltsverzeichnis Einleitung... 3 Bakterien...
Mikrobiologische Befunde verstehen Futtermittel für landwirtschaftliche Nutztiere Referat Fütterung/Beratungsstellen Rinder- und Schweineproduktion Stand: 2016-10 Inhaltsverzeichnis Einleitung... 3 Bakterien...
Einfluss verschiedener Heutrock- nungsverfahren auf Futterwert und Milcherzeugung
 Einfluss verschiedener Heutrock- nungsverfahren auf Futterwert und Milcherzeugung Univ.-Doz. Dr. Leonhard Gruber HBLFA Raumberg-Gumpenstein Versuchsplan Vergleich verschiedener Heutrocknungsverfahren Bodentrocknung
Einfluss verschiedener Heutrock- nungsverfahren auf Futterwert und Milcherzeugung Univ.-Doz. Dr. Leonhard Gruber HBLFA Raumberg-Gumpenstein Versuchsplan Vergleich verschiedener Heutrocknungsverfahren Bodentrocknung
Futterwerttabelle für Wiederkäuer
 Futterwerttabelle für Wiederkäuer Grundfutter, raftfutter Abteilun Tierproduktion/Referat Fütterun Stand: -0 Seite / FUTTERWERTTABELLE FÜR WIEDERÄUER Die vorlieende Futterwerttabelle für Wiederkäuer stellt
Futterwerttabelle für Wiederkäuer Grundfutter, raftfutter Abteilun Tierproduktion/Referat Fütterun Stand: -0 Seite / FUTTERWERTTABELLE FÜR WIEDERÄUER Die vorlieende Futterwerttabelle für Wiederkäuer stellt
Die Fütterung. Von Vanessa Sigl und Magdalena Hackl
 Die Fütterung Von Vanessa Sigl und Magdalena Hackl Allgemeine Grundsätze: leistungsbezogen müssen alle Tiere mit den Nährstoffen und Wirkstoffen versorgt werden die sie brauchen Es dürfen nur einwandfreie
Die Fütterung Von Vanessa Sigl und Magdalena Hackl Allgemeine Grundsätze: leistungsbezogen müssen alle Tiere mit den Nährstoffen und Wirkstoffen versorgt werden die sie brauchen Es dürfen nur einwandfreie
I. Empfehlungen für die Nähr- und Mineralstoffversorgung von Milchkühen
 I. Empfehlungen für die Nähr- und Mineralstoffversorgung von Milchkühen Landwirtschaftskammer Schleswig-Holstein Lebend- Trocken- Energie- und Proteinversorgung Mineralstoffversorgung masse masseauf- NEL
I. Empfehlungen für die Nähr- und Mineralstoffversorgung von Milchkühen Landwirtschaftskammer Schleswig-Holstein Lebend- Trocken- Energie- und Proteinversorgung Mineralstoffversorgung masse masseauf- NEL
Futterwert der Gras- und Maissilagen Der Grobfutterindex Der Kornzerkleinerungsgrad (CSPS)
 Futterwert der Gras- und Maissilagen Der Grobfutterindex Der Kornzerkleinerungsgrad (CSPS) Dr. Wolfram Richardt, 16. Oktober 2018 19.10.2018 [email protected] 1 Mögliche Folgen von Trockenheitsschäden
Futterwert der Gras- und Maissilagen Der Grobfutterindex Der Kornzerkleinerungsgrad (CSPS) Dr. Wolfram Richardt, 16. Oktober 2018 19.10.2018 [email protected] 1 Mögliche Folgen von Trockenheitsschäden
Silierung von Sojabohnen-GPS Wolkertshofen, den
 Bayerische Landesanstalt für Landwirtschaft Silierung von Sojabohnen-GPS Wolkertshofen, den 12.09.2017 1Institut für Tierernährung und Futterwirtschaft 2Abteilung Qualitätssicherung und Untersuchungswesen
Bayerische Landesanstalt für Landwirtschaft Silierung von Sojabohnen-GPS Wolkertshofen, den 12.09.2017 1Institut für Tierernährung und Futterwirtschaft 2Abteilung Qualitätssicherung und Untersuchungswesen
Einsatz von getrockneten Getreideschlempen (Starprot) in der Milchviehfütterung
 Einsatz von getrockneten Getreideschlempen (Starprot) in der Milchviehfütterung Nutztierforschung DI Marc Urdl 1 Gliederung zu meiner Person Grundlagen Literaturübersicht» in situ-erhebungen» Verdauungsversuch»
Einsatz von getrockneten Getreideschlempen (Starprot) in der Milchviehfütterung Nutztierforschung DI Marc Urdl 1 Gliederung zu meiner Person Grundlagen Literaturübersicht» in situ-erhebungen» Verdauungsversuch»
Silohirse - Sortenversuche Hafendorf
 Silohirse - Sortenversuche Hafendorf 216-217 Versuchsziel: In den letzten Jahren verursachte der westliche Maiswurzelbohrer nicht nur bei Körnermais sondern in den kühleren Regionen der Steiermark auch
Silohirse - Sortenversuche Hafendorf 216-217 Versuchsziel: In den letzten Jahren verursachte der westliche Maiswurzelbohrer nicht nur bei Körnermais sondern in den kühleren Regionen der Steiermark auch
Verdauungsphysiologie des Wiederkäuers II
 Verdauungsphysiologie des Wiederkäuers II Futterstruktur Bedeutung und Bewertung Dr. Thomas Jilg Landwirtschaftliches Zentrum für Rinderhaltung, Grünlandwirtschaft, Milchwirtschaft, Wild, Fischerei Baden-Württemberg
Verdauungsphysiologie des Wiederkäuers II Futterstruktur Bedeutung und Bewertung Dr. Thomas Jilg Landwirtschaftliches Zentrum für Rinderhaltung, Grünlandwirtschaft, Milchwirtschaft, Wild, Fischerei Baden-Württemberg
Mais kann auch mit Zuckerrübe - Mischsilierung von Silomais und Zuckerrüben, Verfahrensbeschreibung und Futterwert
 Mais kann auch mit Zuckerrübe - Mischsilierung von Silomais und Zuckerrüben, Verfahrensbeschreibung und Futterwert Fotos: Priepke Antje Priepke, Bernd Losand, Jana Harms 16. Dummerstorfer Seminar Futter
Mais kann auch mit Zuckerrübe - Mischsilierung von Silomais und Zuckerrüben, Verfahrensbeschreibung und Futterwert Fotos: Priepke Antje Priepke, Bernd Losand, Jana Harms 16. Dummerstorfer Seminar Futter
Futterwertuntersuchung Gras
 Futterwertuntersuchung Gras Grundfutterqualität im Visier blgg.agroxpertus.de Grundfutter: günstiger Grundstoff der Milcherzeugung und Ihre Basis zum Erfolg Futtermittellieferanten bestätigen: 2009 wurden
Futterwertuntersuchung Gras Grundfutterqualität im Visier blgg.agroxpertus.de Grundfutter: günstiger Grundstoff der Milcherzeugung und Ihre Basis zum Erfolg Futtermittellieferanten bestätigen: 2009 wurden
Anlage zur Akkreditierungsurkunde D-PL nach DIN EN ISO/IEC 17025:2005
 Deutsche Akkreditierungsstelle GmbH Anlage zur Akkreditierungsurkunde D-PL-19456-01-00 nach DIN EN ISO/IEC 17025:2005 Gültigkeitsdauer: 29.06.2015 bis 18.08.2019 Ausstellungsdatum: 29.06.2015 Urkundeninhaber:
Deutsche Akkreditierungsstelle GmbH Anlage zur Akkreditierungsurkunde D-PL-19456-01-00 nach DIN EN ISO/IEC 17025:2005 Gültigkeitsdauer: 29.06.2015 bis 18.08.2019 Ausstellungsdatum: 29.06.2015 Urkundeninhaber:
Sensorische Bewertung von Silage und Heu. Ing. Reinhard Resch. Sensorik-Seminar Grundfutter. Institut für Pflanzenbau und Kulturlandschaft
 Sensorik-Seminar Grundfutter Sensorische Bewertung von Silage und Heu Ing. Reinhard Resch Institut für Pflanzenbau und Kulturlandschaft Überblick Einführung Grundfutter-Sensorik Bestimmung Vegetationsstadium
Sensorik-Seminar Grundfutter Sensorische Bewertung von Silage und Heu Ing. Reinhard Resch Institut für Pflanzenbau und Kulturlandschaft Überblick Einführung Grundfutter-Sensorik Bestimmung Vegetationsstadium
Futtermittelkunde und Preiswürdigkeit
 Futtermittelkunde und Preiswürdigkeit Andreaas Steinwidder, Bio-Institut LFZ Raumberg-Gumpenstein Andreas Steinwidder Bio-Institut www.raumberg-gumpenstein.at Embryonalentwicklung Starke Differenzierung
Futtermittelkunde und Preiswürdigkeit Andreaas Steinwidder, Bio-Institut LFZ Raumberg-Gumpenstein Andreas Steinwidder Bio-Institut www.raumberg-gumpenstein.at Embryonalentwicklung Starke Differenzierung
Besonderheiten der Heufütterung
 Heugala 2013 - Kitzbühel Besonderheiten der Heufütterung Karl Wurm 1 Gliederung Heuqualitäten aus Sicht der Fütterung Heu in der Kälber- und Jungviehaufzucht Heu in der Milchviehfütterung Resümee 2 04.02.2013
Heugala 2013 - Kitzbühel Besonderheiten der Heufütterung Karl Wurm 1 Gliederung Heuqualitäten aus Sicht der Fütterung Heu in der Kälber- und Jungviehaufzucht Heu in der Milchviehfütterung Resümee 2 04.02.2013
Fachtagung. Pressschnitzel: Neue Erkenntnisse zu einem altbewährten Futtermittel
 Martin-Luther-Universität Halle-Wittenberg Fachtagung Pressschnitzel: Neue Erkenntnisse zu einem altbewährten Futtermittel Institut für Agrar- und Ernährungswissenschaften 20. März 2007, Halle (Saale)
Martin-Luther-Universität Halle-Wittenberg Fachtagung Pressschnitzel: Neue Erkenntnisse zu einem altbewährten Futtermittel Institut für Agrar- und Ernährungswissenschaften 20. März 2007, Halle (Saale)
Hubert Schuster-ITE 3 b
 Erbsen und Ackerbohnen in der Rinderfütterung Hubert Schuster, LfL - ITE 3 Zollhofer Eiweißtag, 10.7.2016 [/kg TM] 1. Eiweiß vom Acker Vergleich (Gruber Tabelle 2015) Erbsen Sojabohn. Süßlupinen Ackerbohn.
Erbsen und Ackerbohnen in der Rinderfütterung Hubert Schuster, LfL - ITE 3 Zollhofer Eiweißtag, 10.7.2016 [/kg TM] 1. Eiweiß vom Acker Vergleich (Gruber Tabelle 2015) Erbsen Sojabohn. Süßlupinen Ackerbohn.
Mais in der Rinderfütterung
 Seite 1 von 9 Mais in der Rinderfütterung Aufgabe 1 Fügen Sie in der Darstellung zur Verdaulichkeit der Maispflanze die folgenden, fehlenden Angaben an der richtigen Stelle ein: Restpflanze, Spindel, Blatt,
Seite 1 von 9 Mais in der Rinderfütterung Aufgabe 1 Fügen Sie in der Darstellung zur Verdaulichkeit der Maispflanze die folgenden, fehlenden Angaben an der richtigen Stelle ein: Restpflanze, Spindel, Blatt,
Pluto s Leckerbissen!
 Pluto s Leckerbissen! Eine optimale Fütterung ist die Basis für ein gesundes Hundeleben. Hunde brauchen ein ausgewogenen Verhältnis von Nähr- und Vitalstoffen, hochverdauliches Eiweiß für die Muskulatur
Pluto s Leckerbissen! Eine optimale Fütterung ist die Basis für ein gesundes Hundeleben. Hunde brauchen ein ausgewogenen Verhältnis von Nähr- und Vitalstoffen, hochverdauliches Eiweiß für die Muskulatur
Topsilagen kein Hexenwerk! Dr. Sabine Rahn
 Topsilagen kein Hexenwerk! Dr. Sabine Rahn Bausteine für eine hohe Milch- / Mastleistung Milchleistung LWK Niedersachsen Seite 2 Diskutiert wird oft nur über die Spitze des Eisberges. Nur war das nicht
Topsilagen kein Hexenwerk! Dr. Sabine Rahn Bausteine für eine hohe Milch- / Mastleistung Milchleistung LWK Niedersachsen Seite 2 Diskutiert wird oft nur über die Spitze des Eisberges. Nur war das nicht
Unwanted. TRITON Error correction sheet ICP-OES V1.1 !!! !!!!!!!! TRITON GmbH Rather Broich Düsseldorf (Germany)
 Unwanted TRITON Error correction sheet ICP-OES V1.1 1 Unerwünschte Schwermetalle Quecksilber zu hoch 4x 15% wöchentlicher Wasserwechsel mit Hg Selen zu hoch 4x 15% wöchentlicher Wasserwechsel mit Se Cadmium
Unwanted TRITON Error correction sheet ICP-OES V1.1 1 Unerwünschte Schwermetalle Quecksilber zu hoch 4x 15% wöchentlicher Wasserwechsel mit Hg Selen zu hoch 4x 15% wöchentlicher Wasserwechsel mit Se Cadmium
